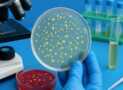
Master Bacteriology :Hands-On Lab Skills for Beginners

[Free] Power Instrumentation &Amp; Electrical Equipments In Power Plant
Power Plant Engineering – Energy Engineering – Power instrumentation – Free Course
What you’ll learn
- To study the Power Station Electrical and Instrumentation part
- To understand the concept of Generator, Transformer, Exciters, Circuit brakers, bus bars, relays, Earthing, Short Circuits etc ,
- To get acquainted with electrical equipments
- To have basic idea of instrumentation
- To get knowledge of Control rooms, role of control room operators and Control system
- Outcomes: After completion of course the learner will be able to
- Understand the basic concepts of various electrical Equipments used in Power plants
- Get acquainted with various methods of cooling of Generator and Transformer
- Understand the importance of electrical protective equipments.
- Get knowledge of Earthing and methods of earthing.
- Know the layout and importance of Control room and Control system employed.
Requirements
- Final Year Mechanical Engineer students
- Diploma Mechanical Students
Description
Unit 6: Instrumentation and Economics of Power Plant
Syllabus points of this course : Power Plant Instruments : layout of electrical equipment, generator, exciter, generator cooling, short circuits & limiting methods, switch gear, circuit breaker, power transformers, methods of earthling, protective devices & control system used in power plants, measurement of high voltage, current and power, control room
The said course is a part of syllabus of Final year Mechanical Engineering students.
The course as mentioned consists of Subject Energy Engineering unit-6.
Unit-6 comprises of total 10 video lectures and resource files. Five video Lectures will be discussed in this course
This unit mainly comprises of various theoretical aspects and based of Electrical and instrument topics.
As per Exam pattern, mostly theoretical questions are asked on this unit.
There are many theoretical topics and also vast. Hence considering time constraint, each lecture is explained in brief and with focus on exam questions.
Objectives of the course are:
To study the Power Station Electrical and Instrumentation part
To understand the concept of Generator , Transformer, Exciters, Circuit brakers, bus bars , relays etc.
To get acquainted with electrical equipments
To have basic idea of instrumentation
To get knowledge of Control rooms and Control system
To study the importance of Load curves and Duration curves
To study various costs incurred in Power plant
To get the knowledge of Tariff and their methods of calculation
To get idea of solving numericals based on power economics.
Course Outcomes
After completion of course the learner will be able to
Understand the basic concepts of various electrical Equipments used in Power plants.
Get acquainted with various methods of cooling of Generator and Transformers.
Understand the importance of electrical protective equipments.
Get knowledge of Earthing and methods of earthing.
Know the layout and importance of Control room and Control system employed.
Get the idea of various costs incurred in Power plant and method solve cost of generation.
Know what is Load curve and Load duration curve and methodology to solve the numericals based on these factors.
Get the Basic ideas cleared on Electrical and Instrumentation system employed in Power plants.
Author(s): Basawraj Racheti